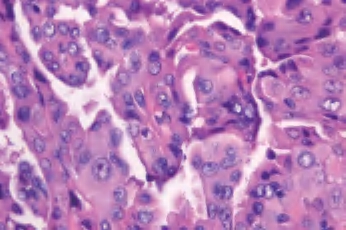

甲状腺乳头状癌是最常见的恶性肿瘤,占甲状腺癌的60%~70%。大多数肿瘤发生在20~50岁的成年人,总的存活率高(>90%)。
1.临床表现 通常为甲状腺肿块或在甲状腺肿中出现一个更明显的结节。放射性碘扫描为“冷”结节或颈部淋巴结病。甲状腺功能试验对诊断没有帮助。
2.肉眼观察 典型的乳头状癌为灰白色、质实,常位于甲状腺包膜附近,切面平整或凹陷,中心部分纤维化较明显,甚至可见到浸润周围甲状腺实质。部分病变有营养不良性钙化,偶见骨化。肿瘤从微小(<1mm)至几厘米不等(图3-38、图3-39)。
3.镜下 为复杂分支状乳头,含纤维血管轴心,细胞拥挤,核增大,呈卵圆形、沙砾体,表面被以单层柱状上皮,半数以上核呈毛玻璃样,有核沟,核内假包涵体(图3-40至图3-43)。

图3-38 甲状腺乳头状癌大体

图3-39 甲状腺乳头状癌大体

图3-40 甲状腺乳头状癌

图3-41 甲状腺乳头状癌

图3-42 甲状腺乳头状癌,箭头处核内假包涵体

图3-43 甲状腺乳头状癌,毛玻璃样核,箭头处为核沟
4.免疫组化 细胞角蛋白(CK)、甲状腺球蛋白(TG)和甲状腺转化因子-1(TTF-1)免疫阳性;而突触素(Syn)和嗜铬素(CgA)阴性;CK19(阳性)、MC(阳性)、TPO(阴性)、Galectin-3(阳性)。
5.预后 10年生存率超过90%,在年轻患者超过98%。与预后有关的重要临床特征取决于年龄、肿瘤大小、甲状腺外侵犯、手术切除的完整性和远隔部位转移。
6.组织学亚型
(1)滤泡亚型:由小至中等大小、不规则滤泡形成,实际上不含乳头结构,滤泡内含胶质,构成滤泡的上皮细胞有大而亮的核,含核沟和核内假包涵体。大约1/3此类肿瘤有包膜,预后与通常的乳头状癌相似(图3-44、图3-45)。
(2)大滤泡亚型:罕见,主要或全部由大滤泡构成,常与增生性结节或大滤泡腺瘤混淆;但滤泡细胞含有大而亮的核和核沟、核内假包涵体。此亚型很少见到淋巴结转移(图3-46、图3-47)。

图3-44 甲状腺乳头状癌,滤泡亚型

图3-45 甲状腺乳头状癌,滤泡亚型

图3-46 甲状腺乳头状癌,大滤泡亚型

图3-47 甲状腺乳头状癌,大滤泡亚型
(3)嗜酸细胞亚型:大体特征是特有的红棕色外观,可呈乳头状或滤泡样结构,镜下乳头是由嗜酸细胞衬覆纤维血管间质形成,含有丰富的慢性炎细胞,常伴有桥本甲状腺炎。癌细胞呈多角形,也可以是柱状,细胞核的特征与通常的乳头状癌相似(图3-48至图3-50)。
(4)透明细胞亚型:滤泡上皮细胞主要由透明细胞构成,细胞内或外可以见到阿辛蓝阳性的黏液(图3-51、图3-52)。
(5)其他亚型:包括高细胞亚型、弥漫硬化型、柱状细胞亚型、筛状型及实体亚型,这些亚型比较罕见。

图3-48 甲状腺乳头状癌,嗜酸细胞亚型

图3-49 甲状腺乳头状癌,嗜酸细胞亚型
图3-50 甲状腺乳头状癌,嗜酸细胞亚型

图3-51 甲状腺乳头状癌,透明细胞亚型

图3-52 甲状腺乳头状癌,透明细胞亚型